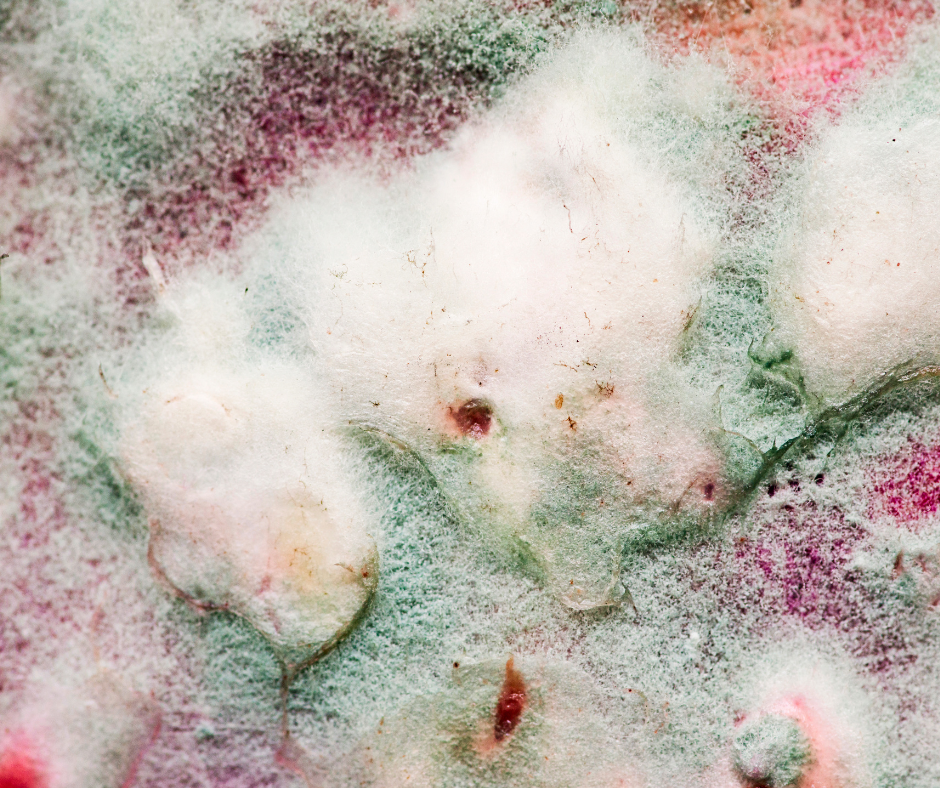

Vermicomposting: Troubleshooting
Section 10 of the Vermicomposting: Complete Guide

L.J.
Environmental Advocate








Contents
🪱 Vermicomposting Troubleshooting Guide
Even the most well-managed worm bin can hit a few snags—whether it’s fruit flies, soggy bedding, or sluggish worms. Vermicomposting is a living system, and small imbalances can affect how your worms behave and how efficiently your bin breaks down food waste.
This guide helps you identify common issues, understand what’s causing them, and apply simple, worm-friendly fixes. Whether your bin smells off, looks too wet, or your worms seem unhappy, you’ll find practical solutions to get things back on track—without harming your composting crew.
😷 Bad Odour in Your Bin?
Troubleshooting: Bad Odour
A strong, unpleasant smell coming from your compost or worm bin is usually a sign that something’s out of balance.
Instead of the earthy scent of healthy decomposition, you might notice sour, rotting, or fermented odours—often caused by excess moisture, poor airflow, or anaerobic conditions.
To pinpoint what’s gone wrong, use this table to match the type of smell with its likely cause ➡️
This will help you identify the issue quickly and apply the right fix to restore a healthy, balanced bin.
💧Moisture Matters: Finding the Right Balance
Moisture is one of the most important factors in successful composting—but it’s also one of the easiest to get wrong. Whether your bin is too wet and turning slimy, or too dry and struggling to break down materials, the balance affects everything from microbial activity to airflow and temperature
This table helps you identify when your compost bin is unbalanced, the likely cause, and how to restore it to the ideal texture: Like a wrung-out sponge.
Achieving the right moisture balance will help your composting system stay active, odour-free, and efficient.
Troubleshooting: Moisture
⚠️ Worm Warning Signs to Look Out For
Worms Tangled in Clumps or Knots
🪢 Worms Tangled in Clumps or Knots
When worms gather in tight, tangled clusters, it’s often a sign that something in the bin environment is making them uncomfortable.
 Sign:
Sign:
Worms are balled up or knotted together in clumps
 Causes:
Causes:
- Bedding too wet or compacted, reducing airflow
- Overcrowding forcing worms into tight spaces
- Anaerobic (oxygen-poor) zones forming in the bin
- Strong odours or spoiled food repelling worms from other areas
 Solution:
Solution:
- Fluff bedding to improve airflow and oxygen levels
- Add dry browns (e.g. shredded cardboard) to absorb excess moisture
- Harvest castings if bedding is dense or compacted
- Reduce feeding amounts and remove any spoiled scraps
- Consider splitting the population if overcrowding persists
Worms Surfacing after Heavy Feeding
⬆️ Worms Surfacing After Heavy Feeding
If worms rise to the surface after a large feeding session, it’s often a sign that the bin environment has shifted and become uncomfortable.
 Sign:
Sign:
Worms moving to the surface soon after food is added
 Causes:
Causes:
- Rapid decomposition creating heat or anaerobic (oxygen-poor) zones
- Overfeeding leading to protein poisoning or sour bedding
- Compacted or soggy bedding reducing airflow
- Strong odours repelling worms from the feeding zone
 Solution:
Solution:
- Reduce feeding amounts and avoid piling food in one area
- Fluff bedding to improve airflow and oxygen levels
- Add dry browns to absorb excess moisture
- Remove spoiled or smelly scraps promptly
- Let bin settle before adding more food
Worms on Lids or in Corners
🧱 Worms on Lids and Walls
If worms are climbing the bin walls or gathering around the lid, it’s a clear sign they’re trying to escape uncomfortable conditions inside the bin.
 Sign:
Sign:
Worms crawling up bin walls or clustering around the lid
 Causes:
Causes:
- Excess moisture or soggy bedding creating anaerobic zones
- Strong odours from spoiled food or acidic bedding
- Poor airflow or low oxygen levels in the bedding
- Temperature extremes or sudden environmental changes
- Overcrowding or bedding imbalance
 Solution:
Solution:
- Add dry bedding to absorb moisture and fluff to improve airflow
- Remove spoiled or smelly food scraps promptly
- Check bin placement—avoid direct sun, cold drafts, or vibrations
- Harvest castings if bedding is dense or compacted
- Ensure lid allows for ventilation without letting worms escape
Leachate in Sump/Collector
💧 Leachate in Sump/Collector Tray
Excess liquid accumulating at the bottom of your worm bin can create several problems. It may drown your worms or attract unwanted pests like fruit flies or ants, disrupting the balance of your worm bin.
➕ Add dry bedding (e.g., shredded cardboard, dry leaves) to absorb extra moisture and help maintain a balanced environment.
💦 Drain excess from sump/collector tray
⬆️ Elevate bins without sump/collector trays
Leachate vs Worm Tea
🤔 Leachate vs Worm Tea: What’s the Difference?
Leachate is the liquid that collects in the sump or drainage tray of a worm bin.
It’s often a mix of excess moisture, partially broken-down food juices, and microbial runoff. Because it can contain anaerobic bacteria or pathogens—especially if the bin is too wet—it’s not recommended for use on edible plants without treatment.
✅ Safe Use Tips For Leachate:
- Use cautiously—only on non-edible plants, and dilute 1:10 with water.
- Never apply if it smells sour or rotten.

Worm tea, on the other hand, is a deliberately brewed liquid- rich in nutrients and safe to use on vegetables, herbs, and houseplants.
For a detailed, step-by-step guide on making worm tea, see Section 7: Harvesting Vermicast.
✅ Safe Use Tips For Worm Tea:
- Brew fresh, use within 24 hours, and apply directly to soil or as a foliar spray.
- Safe for all plants when properly made.
🩺 Worried about Worm Health?
Healthy composting worms are active, plump, and quietly working through your food waste. But if they start to slow down, lose colour, or behave unusually, it’s often a sign that something in your bin needs adjusting.
This section helps you recognise early signs of poor worm health, understand the underlying causes, and apply gentle, effective fixes. Whether it’s bedding imbalances, overfeeding, or temperature stress, small changes can make a big difference.
This table outlines common signs that your worms are struggling, along with their likely causes and simple, practical solutions to help restore a healthy, thriving wormery.
Troubleshooting: Worm Health
⚠️ Worm Signs to Look Out For:
Sluggish or Inactive Worms
🥱 Sluggish or Inactive Worms
If your worms are moving very slowly or staying still for long periods, it usually means something is off with the bin environment.
⚠️ Sign:
Worms are sluggish, inactive, or barely moving
➡️ Causes:
- Cold temperatures slowing down worm metabolism
- Bedding too dry or too wet, causing discomfort
- Poor airflow leading to low oxygen levels
- Overfeeding causing toxic build-up or ammonia
- Acidic or imbalanced bedding conditions
✅ Solution:
- Move the bin to a warmer, stable spot (ideally 15–25°C)
- Adjust moisture levels: add dry bedding if too wet, or sprinkle water if too dry
- Fluff or turn the bedding to improve airflow and oxygenation
- Reduce feeding amounts and remove any spoiled food promptly
- Test and balance pH by adding crushed eggshells or garden lime if needed
Unusually Thin or Pale Worns
🪱 Worms Unusually Thin or Pale
If worms appear thinner than usual or lose their healthy reddish colour, it’s often a sign of poor nutrition or stress in the bin.
⚠️ Sign:
Worms look pale, washed-out, or unusually thin
➡️ Causes:
- Poor nutrition from limited or unsuitable food scraps
- Prolonged stress due to acidic bedding or overcrowding
- Low oxygen levels from compacted or soggy bedding
- Cold temperatures slowing metabolism and digestion
✅ Solution:
- Add a variety of soft, worm-friendly food scraps (avoid citrus/onions)
- Fluff bedding to improve airflow and reduce compaction
- Harvest castings if bedding is dense or anaerobic
- Move bin to a warmer, stable location (15–25°C ideal)
- Add crushed eggshells or garden lime to buffer acidity if needed
Restless Surface Movement at Night
🌒Restless Surface Movement at Night
Worms moving actively on the surface during the night can indicate stress or discomfort in the bin environment.
⚠️ Sign:
Increased worm activity on the surface after dark
➡️ Causes:
- Overcrowding pushing worms upward
- Bedding too wet, compacted, or lacking airflow
- Anaerobic (oxygen-poor) conditions underground
✅ Solutions:
- Improve bin ventilation to increase airflow
- Add dry bedding to absorb excess moisture
- Reduce feeding amounts to prevent overcrowding and spoilage
Worms Outside the Bin or on the Floor
🗑️ Worms Found Outside the Bin or on the Floor
Worms escaping the bin entirely signals serious discomfort or unsuitable conditions inside.
⚠️ Sign:
Worms found outside the bin, on the lid, or crawling on nearby surfaces
➡️ Causes:
- Excess moisture or soggy bedding
- Strong odours from spoiled food or anaerobic pockets
- Temperature extremes or sudden environmental changes
- Poor airflow or compacted bedding
- Bright light or vibrations during transport/setup
✅ Solutions:
- Add dry browns to rebalance moisture
- Remove spoiled food and fluff bedding to restore airflow
- Keep bin in a stable, shaded location away from heat or cold
- Let bin settle after setup or reset before feeding
- Use a breathable lid and check for escape gaps
Increased Activity near Vents
🌬️ Increased Activity Near Vents or Gaps
Worms gathering near ventilation holes or bin gaps may be seeking better airflow or trying to escape poor conditions inside.
⚠️ Sign:
Worms clustering or moving near vents, lid gaps, or bin edges
➡️ Causes:
- Poor airflow or compacted bedding creating oxygen-poor zones
- Excess moisture or soggy bedding driving worms upward
- Strong odours or acidic conditions repelling worms from the core
- Temperature discomfort or sudden environmental changes
✅ Solutions:
- Fluff bedding and add dry browns to improve airflow and absorb moisture
- Remove strong-smelling or acidic food scraps
- Ensure vents are unobstructed and bin is in a stable, shaded location
- Let bin settle after setup or reset before feeding
⚠️ Protein Poisoning in Worms
Protein poisoning in worms, sometimes called string-of-pearls syndrome, happens when too much protein-rich food—like meat, dairy, or legumes—breaks down without enough oxygen. This anaerobic decay produces harmful gases such as ammonia, which can stress or even kill your worms, leading to bloating and sluggishness.
Signs of Protein Poisoning
🔎 Signs of Protein Poisoning
- Worms appear bloated or segmented like a string of pearls
- They may become sluggish, disoriented, or die off suddenly
- Strong ammonia-like smell in the bin
Common Causes of Protein Poisoning
🚫 Common Causes of Protein Poisoning
- Overfeeding with high-protein scraps (e.g. meat, dairy, legumes, grains)
- Poor aeration or compacted bedding
- Excess moisture leading to anaerobic conditions
How to Fix and Prevent Protein Poisoning
✅ How to Fix and Prevent Protein Poisoning
- Remove affected food scraps immediately
- Add dry bedding (shredded cardboard, paper) to absorb moisture and restore balance
- Aerate the bin gently to improve airflow
- Feed in moderation, especially during cooler months
- Avoid meat, dairy, and cooked grains.
🚪Why are my Worms Escaping?
Worms occasionally wander, but frequent or mass escapes are a sign that something in your bin isn’t right. Whether it’s poor airflow, excess acidity, or unsuitable bedding, your composting crew may be trying to flee uncomfortable conditions.
The table below outlines common escape triggers, their likely causes, and simple, effective solutions to help restore a safe, balanced environment—so your worms stay happy and at home.
Troubleshooting: Worm Escapes

⚠️ Worm Signs to Look Out For:
Worms Avoiding Food Zones
 Worms Avoiding Food Zones
Worms Avoiding Food Zones
If worms consistently steer clear of fresh scraps, it usually signals something is off with the food or bedding.
 Sign:
Sign:
Worms avoiding feeding zone
 Causes:
Causes:
- Acidity build-up from citrus, onions, or acidic foods
- Spoiled food creating unpleasant smells
- Foods worms dislike or cannot easily break down
 Solution:
Solution:
- Check and balance pH levels in the bin
- Rotate food types regularly to avoid build-up
- Remove spoiled or rotten scraps promptly to prevent odours
Worms Surfacing during Daylight
☀️ Worms Surfacing during Daylight?
Worms are naturally nocturnal, so seeing them on the surface during daylight is unusual and often a sign of stress.
⚠️ Sign:
Worms surfacing during daylight
➡️ Causes:
- Overcrowding pushes worms closer to the surface
- Poor bedding that is too wet, compacted, or lacking airflow
- Anaerobic (oxygen-poor) conditions underground causing discomfort
✅ Solutions:
- Improve bin ventilation to increase airflow
- Add dry bedding to absorb excess moisture
- Reduce feeding volume to prevent overcrowding and spoilage
Restless Surface Movement at Night
🌒 Restless Surface Movement at Night
Worms moving actively on the surface during the night can indicate stress or discomfort in the bin environment.
⚠️ Sign:
Increased worm activity on the surface after dark
➡️ Causes:
- Overcrowding pushing worms upward
- Bedding too wet, compacted, or lacking airflow
- Anaerobic (oxygen-poor) conditions underground
✅ Solutions:
- Improve bin ventilation to increase airflow
- Add dry bedding to absorb excess moisture
- Reduce feeding amounts to prevent overcrowding and spoilage
Worms Outside the Bin or on the Floor
🗑️ Worms Found Outside the Bin or on the Floor
Worms escaping the bin entirely signals serious discomfort or unsuitable conditions inside.
⚠️ Sign:
Worms found outside the bin, on the lid, or crawling on nearby surfaces
➡️ Causes:
- Excess moisture or soggy bedding
- Strong odours from spoiled food or anaerobic pockets
- Temperature extremes or sudden environmental changes
- Poor airflow or compacted bedding
- Bright light or vibrations during transport/setup
✅ Solutions:
- Add dry browns to rebalance moisture
- Remove spoiled food and fluff bedding to restore airflow
- Keep bin in a stable, shaded location away from heat or cold
- Let bin settle after setup or reset before feeding
- Use a breathable lid and check for escape gaps
Increased Activity near Vents
🌬️ Increased Activity Near Vents or Gaps
Worms gathering near ventilation holes or bin gaps may be seeking better airflow or trying to escape poor conditions inside.
⚠️ Sign:
Worms clustering or moving near vents, lid gaps, or bin edges
➡️ Causes:
- Poor airflow or compacted bedding creating oxygen-poor zones
- Excess moisture or soggy bedding driving worms upward
- Strong odours or acidic conditions repelling worms from the core
- Temperature discomfort or sudden environmental changes
✅ Solutions:
- Fluff bedding and add dry browns to improve airflow and absorb moisture
- Remove strong-smelling or acidic food scraps
- Ensure vents are unobstructed and bin is in a stable, shaded location
- Let bin settle after setup or reset before feeding
🐜 Unwanted Guests
Troubleshooting: Pests
A healthy compost bin or wormery should be teeming with microbes—not buzzing with fruit flies or crawling with mites. While some tiny critters are harmless (even helpful), others can signal an imbalance in moisture, feeding, or airflow.
This section helps you identify which pests are present, understand why they’ve appeared, and apply simple, bin-safe solutions to bring things back into balance. The Worm Bin Pest Troubleshooting Table outlines common compost pests, their likely causes, and effective ways to manage or prevent them—without harming your worms or disrupting the composting process.
🔍 From Helpful to Harmful: Who’s Who in Your Bin
🪱🛑Worm Warning Signs: What to Watch For
Healthy worms are active, reddish, and quietly working through your bedding. But when conditions shift—too wet, too dry, too crowded—they’ll let you know. This section helps you spot early signs of stress, discomfort, or imbalance before problems escalate.
Use these clues to troubleshoot moisture, airflow, feeding, and temperature issues. Each sign links to common causes and practical fixes tailored for UK wormeries.

⚠️ Worm Behaviour Warning Signs
Avoiding Food Zones
 Worms Avoiding Food Zones
Worms Avoiding Food Zones
If worms consistently steer clear of fresh scraps, it usually signals something is off with the food or bedding.
 Sign:
Sign:
Worms avoiding feeding zone
 Causes:
Causes:
- Acidity build-up from citrus, onions, or acidic foods
- Spoiled food creating unpleasant smells
- Foods worms dislike or cannot easily break down
 Solution:
Solution:
- Check and balance pH levels in the bin
- Rotate food types regularly to avoid build-up
- Remove spoiled or rotten scraps promptly to prevent odours
Burrowing Deep & Staying Hidden
🕳️ Burrowing Deep and Staying Hidden
If worms are rarely seen near the surface and seem to stay buried, it’s usually a sign they’re responding to environmental stress or seasonal shifts.
 Sign:
Sign:
Worms remain deep in the bedding and avoid surface activity
 Causes:
Causes:
- Cold temperatures slowing metabolism and surface feeding
- Dry bedding prompting worms to seek moisture deeper down
- Overfeeding or anaerobic zones near the surface
- Strong light exposure or vibrations disturbing surface zones
- Natural behaviour during colder months or bin resets
 Solution:
Solution:
- Check bin temperature—ideal range is 15–25°C
- Lightly moisten bedding if it feels dry or crumbly
- Fluff bedding to improve airflow and reduce compaction
- Avoid overfeeding and remove any spoiled food
- Keep bin in a shaded, stable location away from disturbance
Clustering Tightly in One Area
🛑 Clustering in One Area
If worms are gathering in a single spot and avoiding the rest of the bin, it often signals that conditions elsewhere have become uncomfortable or unbalanced.
 Sign:
Sign:
Worms tightly grouped in one zone, avoiding other areas of the bin
 Causes:
Causes:
- Anaerobic or acidic zones forming in parts of the bedding
- Uneven moisture levels—too wet or too dry in certain areas
- Strong odours or spoiled food repelling worms from specific zones
- Poor airflow or compacted bedding in neglected areas
- Temperature imbalance within the bin
 Solution:
Solution:
- Fluff and mix bedding to restore airflow and even out conditions
- Remove spoiled or smelly food scraps from avoided zones
- Add dry bedding to absorb excess moisture or sprinkle water if too dry
- Check bin placement for temperature stability
- Rotate feeding locations to prevent build-up in one area
Clumping at Edges
⚠️ Clumping at Edges
When worms gather in tight groups around the bin’s edges, it often signals discomfort or imbalance in the core bedding area.
 Sign:
Sign:
Worms clustering around bin walls, corners, or under the lid
 Causes:
Causes:
- Anaerobic or compacted bedding driving worms away from the centre
- Excess moisture or strong odours repelling worms from food zones
- Poor airflow or low oxygen levels in the core bedding
- Overcrowding or temperature discomfort
 Solution:
Solution:
- Fluff bedding to improve airflow and oxygenation
- Add dry browns to absorb excess moisture
- Remove spoiled or smelly food scraps
- Harvest castings if bedding is dense or compacted
- Check bin placement for stable temperature and ventilation
Found Outside the Bin or on the Floor
🗑️ Worms Found Outside the Bin or on the Floor
Worms escaping the bin entirely signals serious discomfort or unsuitable conditions inside.
⚠️ Sign:
Worms found outside the bin, on the lid, or crawling on nearby surfaces
➡️ Causes:
- Excess moisture or soggy bedding
- Strong odours from spoiled food or anaerobic pockets
- Temperature extremes or sudden environmental changes
- Poor airflow or compacted bedding
- Bright light or vibrations during transport/setup
✅ Solutions:
- Add dry browns to rebalance moisture
- Remove spoiled food and fluff bedding to restore airflow
- Keep bin in a stable, shaded location away from heat or cold
- Let bin settle after setup or reset before feeding
- Use a breathable lid and check for escape gaps
On Lids & Walls
🧱 Worms on Lids and Walls
If worms are climbing the bin walls or gathering around the lid, it’s a clear sign they’re trying to escape uncomfortable conditions inside the bin.
 Sign:
Sign:
Worms crawling up bin walls or clustering around the lid
 Causes:
Causes:
- Excess moisture or soggy bedding creating anaerobic zones
- Strong odours from spoiled food or acidic bedding
- Poor airflow or low oxygen levels in the bedding
- Temperature extremes or sudden environmental changes
- Overcrowding or bedding imbalance
 Solution:
Solution:
- Add dry bedding to absorb moisture and fluff to improve airflow
- Remove spoiled or smelly food scraps promptly
- Check bin placement—avoid direct sun, cold drafts, or vibrations
- Harvest castings if bedding is dense or compacted
- Ensure lid allows for ventilation without letting worms escape
Increased Activity near Vents
🌬️ Increased Activity Near Vents or Gaps
Worms gathering near ventilation holes or bin gaps may be seeking better airflow or trying to escape poor conditions inside.
⚠️ Sign:
Worms clustering or moving near vents, lid gaps, or bin edges
➡️ Causes:
- Poor airflow or compacted bedding creating oxygen-poor zones
- Excess moisture or soggy bedding driving worms upward
- Strong odours or acidic conditions repelling worms from the core
- Temperature discomfort or sudden environmental changes
✅ Solutions:
- Fluff bedding and add dry browns to improve airflow and absorb moisture
- Remove strong-smelling or acidic food scraps
- Ensure vents are unobstructed and bin is in a stable, shaded location
- Let bin settle after setup or reset before feeding
In Sump/Collector Tray
💧 Worms in Sump or Drainage Tray
If worms are found in the sump or collector tray, it usually means they’ve been driven downward by uncomfortable conditions in the main bedding area.
 Sign:
Sign:
Worms gathering in the sump or drainage tray beneath the bin
 Causes:
Causes:
- Excess moisture or soggy bedding pushing worms away from the surface
- Compacted bedding reducing airflow and oxygen levels
- Anaerobic zones forming due to poor drainage or overfeeding
- Lack of dry refuge or uneven bedding structure
 Solution:
Solution:
- Add dry bedding (e.g. shredded cardboard) to absorb excess moisture
- Fluff or turn bedding to improve airflow and oxygenation
- Drain leachate regularly to prevent waterlogging
- Harvest castings if bedding is dense or compacted
- Elevate bin slightly to improve drainage and airflow underneath
Mass Exodus
😲 Mass Exodus (Worms Escaping the Bin)
If multiple worms are found outside the bin, on the lid, or crawling on nearby surfaces, it’s a strong sign that something inside the bin is seriously off.
 Sign:
Sign:
Worms escaping in large numbers—found on the lid, bin walls, or surrounding area
 Causes:
Causes:
- Excess moisture or soggy bedding creating anaerobic conditions
- Strong odours from spoiled food or acidic bedding
- Temperature extremes (too hot or too cold)
- Poor airflow or compacted bedding
- Vibrations, bright light, or sudden environmental changes
 Solution:
Solution:
- Add dry bedding to absorb excess moisture and fluff to improve airflow
- Remove spoiled or smelly food scraps promptly
- Move bin to a stable, shaded location away from heat or cold
- Let bin settle after setup or reset before feeding
- Check for escape gaps and ensure the lid allows for ventilation
Restless Surface Movement at Night
🌒 Restless Surface Movement at Night
Worms moving actively on the surface during the night can indicate stress or discomfort in the bin environment.
⚠️ Sign:
Increased worm activity on the surface after dark
➡️ Causes:
- Overcrowding pushing worms upward
- Bedding too wet, compacted, or lacking airflow
- Anaerobic (oxygen-poor) conditions underground
✅ Solutions:
- Improve bin ventilation to increase airflow
- Add dry bedding to absorb excess moisture
- Reduce feeding amounts to prevent overcrowding and spoilage
Sluggish or Inactive Worms
🥱 Sluggish or Inactive Worms
If your worms are moving very slowly or staying still for long periods, it usually means something is off with the bin environment.
⚠️ Sign:
Worms are sluggish, inactive, or barely moving
➡️ Causes:
- Cold temperatures slowing down worm metabolism
- Bedding too dry or too wet, causing discomfort
- Poor airflow leading to low oxygen levels
- Overfeeding causing toxic build-up or ammonia
- Acidic or imbalanced bedding conditions
✅ Solution:
- Move the bin to a warmer, stable spot (ideally 15–25°C)
- Adjust moisture levels: add dry bedding if too wet, or sprinkle water if too dry
- Fluff or turn the bedding to improve airflow and oxygenation
- Reduce feeding amounts and remove any spoiled food promptly
- Test and balance pH by adding crushed eggshells or garden lime if needed
Surfacing after Heavy Feeding
⬆️ Worms Surfacing After Heavy Feeding
If worms rise to the surface after a large feeding session, it’s often a sign that the bin environment has shifted and become uncomfortable.
 Sign:
Sign:
Worms moving to the surface soon after food is added
 Causes:
Causes:
- Rapid decomposition creating heat or anaerobic (oxygen-poor) zones
- Overfeeding leading to protein poisoning or sour bedding
- Compacted or soggy bedding reducing airflow
- Strong odours repelling worms from the feeding zone
 Solution:
Solution:
- Reduce feeding amounts and avoid piling food in one area
- Fluff bedding to improve airflow and oxygen levels
- Add dry browns to absorb excess moisture
- Remove spoiled or smelly scraps promptly
- Let bin settle before adding more food
Surfacing during Daylight
☀️ Worms Surfacing during Daylight?
Worms are naturally nocturnal, so seeing them on the surface during daylight is unusual and often a sign of stress.
⚠️ Sign:
Worms surfacing during daylight
➡️ Causes:
- Overcrowding pushes worms closer to the surface
- Poor bedding that is too wet, compacted, or lacking airflow
- Anaerobic (oxygen-poor) conditions underground causing discomfort
✅ Solutions:
- Improve bin ventilation to increase airflow
- Add dry bedding to absorb excess moisture
- Reduce feeding volume to prevent overcrowding and spoilage
Tangled In Clumps or Knots
🪢 Worms Tangled in Clumps or Knots
When worms gather in tight, tangled clusters, it’s often a sign that something in the bin environment is making them uncomfortable.
 Sign:
Sign:
Worms are balled up or knotted together in clumps
 Causes:
Causes:
- Bedding too wet or compacted, reducing airflow
- Overcrowding forcing worms into tight spaces
- Anaerobic (oxygen-poor) zones forming in the bin
- Strong odours or spoiled food repelling worms from other areas
 Solution:
Solution:
- Fluff bedding to improve airflow and oxygen levels
- Add dry browns (e.g. shredded cardboard) to absorb excess moisture
- Harvest castings if bedding is dense or compacted
- Reduce feeding amounts and remove any spoiled scraps
- Consider splitting the population if overcrowding persists
Unusually Thin or Pale over time
🔹Worms Unusually Thin or Pale
If worms appear thinner than usual or lose their healthy reddish colour, it’s often a sign of poor nutrition or stress in the bin.
⚠️ Sign:
Worms look pale, washed-out, or unusually thin
➡️ Causes:
- Poor nutrition from limited or unsuitable food scraps
- Prolonged stress due to acidic bedding or overcrowding
- Low oxygen levels from compacted or soggy bedding
- Cold temperatures slowing metabolism and digestion
✅ Solution:
- Add a variety of soft, worm-friendly food scraps (avoid citrus/onions)
- Fluff bedding to improve airflow and reduce compaction
- Harvest castings if bedding is dense or anaerobic
- Move bin to a warmer, stable location (15–25°C ideal)
- Add crushed eggshells or garden lime to buffer acidity if needed
🔄 Beyond Worm Behaviour: When the Bin Itself Needs Attention
Worms are great messengers—but not all issues show up through their behaviour. If your bin seems sluggish, scraps linger, or mould takes over, it’s time to look at the environment itself. Bedding balance, airflow, moisture, and feeding rhythm all play a role in healthy decomposition.
🐢 Slow Decomposition
If your scraps are lingering longer than expected, it’s often due to cold temperatures, poor airflow, or an imbalanced mix of inputs. Worms slow down in cooler weather, and dense or overly wet bedding can stall microbial activity.
Quick Fixes:
• Chop scraps smaller to speed up breakdown
• Balance greens and browns to support microbial life
• Insulate your bin in winter to maintain worm activity
• Avoid overfeeding—too much at once can overwhelm the system
🔎 Mould on Food Scraps
Mould is part of natural decomposition, but when it takes over, it’s often a sign your worm bin needs a tweak. This section outlines the most common reasons mould appears—whether it’s too much food, not enough moisture, or slow worm activity—so you can rebalance your bin before it affects worm health
➡️ Causes:
Usually triggered by overfeeding, dry bedding, poor airflow, cold temperatures, or scraps left uncovered.

✅ Solutions:
- Remove heavily mouldy scraps if worms are avoiding them
- Mix food into bedding to reduce surface mould and aid decomposition
- Lightly moisten bedding if it feels dry or crumbly
- Fluff bedding to improve airflow and oxygen levels
- Feed smaller amounts more frequently, especially in cooler months
- Cover fresh scraps with bedding to discourage surface mould
- Avoid piling high-sugar or starchy foods like bread and fruit
🌱 Final Note: You’ve Got This
Worm composting is a journey—sometimes squirmy, sometimes surprising, always rewarding. With the right signs to watch for and simple steps to restore balance, you’re well-equipped to keep your wormery thriving.
Whether you’re teaching, troubleshooting, or just starting out, this guide is here to support you every step of the way. Keep observing, keep adjusting, and trust your instincts. Your worms will show you what they need—and now, you know how to listen.














